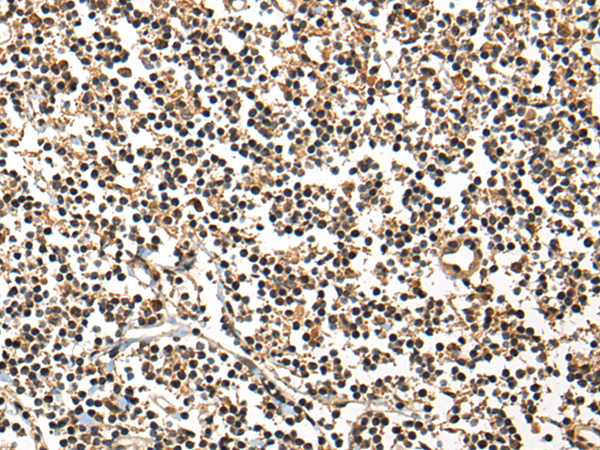

中文名稱:兔抗CPE多克隆抗體
|
Background: |
This gene encodes a member of the M14 family of metallocarboxypeptidases. The encoded preproprotein is proteolytically processed to generate the mature peptidase. This peripheral membrane protein cleaves C-terminal amino acid residues and is involved in the biosynthesis of peptide hormones and neurotransmitters, including insulin. This protein may also function independently of its peptidase activity, as a neurotrophic factor that promotes neuronal survival, and as a sorting receptor that binds to regulated secretory pathway proteins, including prohormones. Mutations in this gene are implicated in type 2 diabetes. |
|
Applications: |
ELISA, WB, IHC |
|
Name of antibody: |
CPE |
|
Immunogen: |
Fusion protein of human CPE |
|
Full name: |
carboxypeptidase E |
|
Synonyms: |
CPH |
|
SwissProt: |
P16870 |
|
ELISA Recommended dilution: |
5000-10000 |
|
IHC positive control: |
Human colorectal cancer and Human tonsil |
|
IHC Recommend dilution: |
25-100 |
|
WB Predicted band size: |
53 kDa |
|
WB Positive control: |
NIH/3T3 cell lysate |
|
WB Recommended dilution: |
200-1000 |

購物車
幫助
021-54845833/15800441009
